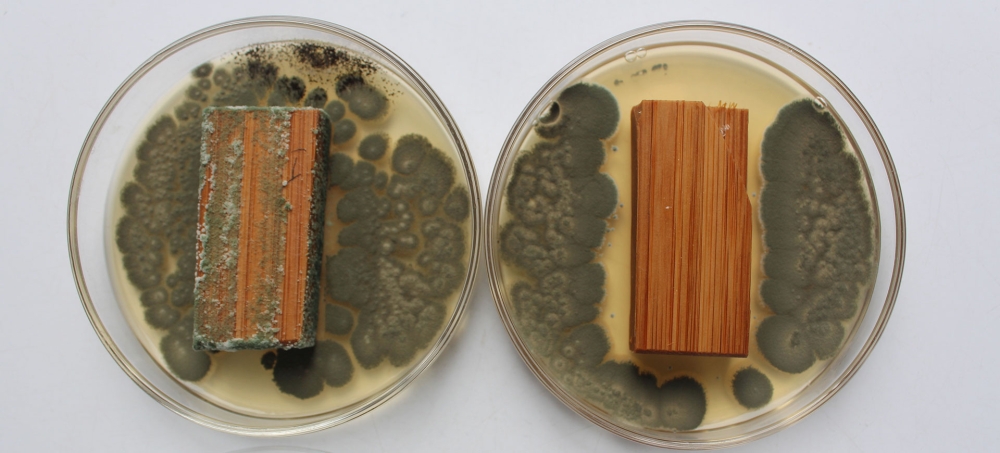

医用抗菌洁净板
在医疗环境中,洁净室的维护是确保患者安全和医护人员健康的关键因素之一。医用抗菌洁净板作为医疗建筑中不可或缺的材料,其表面处理技术对防止霉菌滋生至关重要。本文将探讨潮湿、环境或材料特性导致霉菌滋生的影响,以及如何通过防霉剂的应用来有效抑制霉菌的生长。
一、霉菌滋生的影响
潮湿环境是霉菌生长的理想条件。在手术室、病房、实验室等场所,由于湿度较高,空气中的水分容易凝结在表面上。如果这些表面没有得到适当的保护,就容易成为霉菌的滋生地。霉菌不仅会导致材料表面颜色变化、出现斑点,还可能产生有毒的孢子,这些孢子可以通过空气传播,影响患者的健康。此外,霉菌还会破坏材料的结构和功能,缩短材料的使用寿命,增加维护成本。
二、防霉剂的作用机理与价值
防霉剂是一种能够抑制或杀死霉菌生长的物质。它通常包含多种成分,如有机酸、季铵盐化合物、生物酶等,这些成分能够破坏霉菌细胞的结构,阻止其繁殖。防霉剂的应用不仅可以减少霉菌滋生的风险,还可以保持材料的外观整洁和延长其使用寿命。
三、实际应用与处置意见
为了应对潮湿环境中的霉菌问题,医疗机构可以采取以下措施:
1. 定期检查和维护:定期检查医用抗菌洁净板的外观和结构,发现霉菌迹象及时进行处理。
2. 使用防霉剂:在安装前对表面进行防霉处理,使用专业的防霉剂喷涂或涂抹在板材上,形成一层保护膜。
3. 优化通风系统:加强室内外的通风换气,降低室内湿度,减少霉菌滋生的机会。
4. 定期清洁和消毒:定期对医用抗菌洁净板进行清洁和消毒,以去除表面的污染物和微生物。
四、防霉应用案例分析
在某大型医院的案例中,由于手术室湿度控制不当,出现了严重的霉菌污染问题。医院采取了上述措施后,成功减少了霉菌的滋生,保持了手术室的清洁和无菌环境。此外,医院还引入了一种新型的防霉剂,经过临床试验证明,能有效抑制霉菌生长,且对人体无害。
五、结语
医用抗菌洁净板在医疗环境中发挥着重要作用,而防霉剂的应用则是确保其长期稳定运行的关键。通过科学的防霉措施,可以有效降低霉菌滋生的风险,保障患者的安全和医护人员的健康。未来,随着科技的进步,我们期待看到更多高效、环保的防霉剂被开发和应用,为医疗环境的洁净保驾护航。
